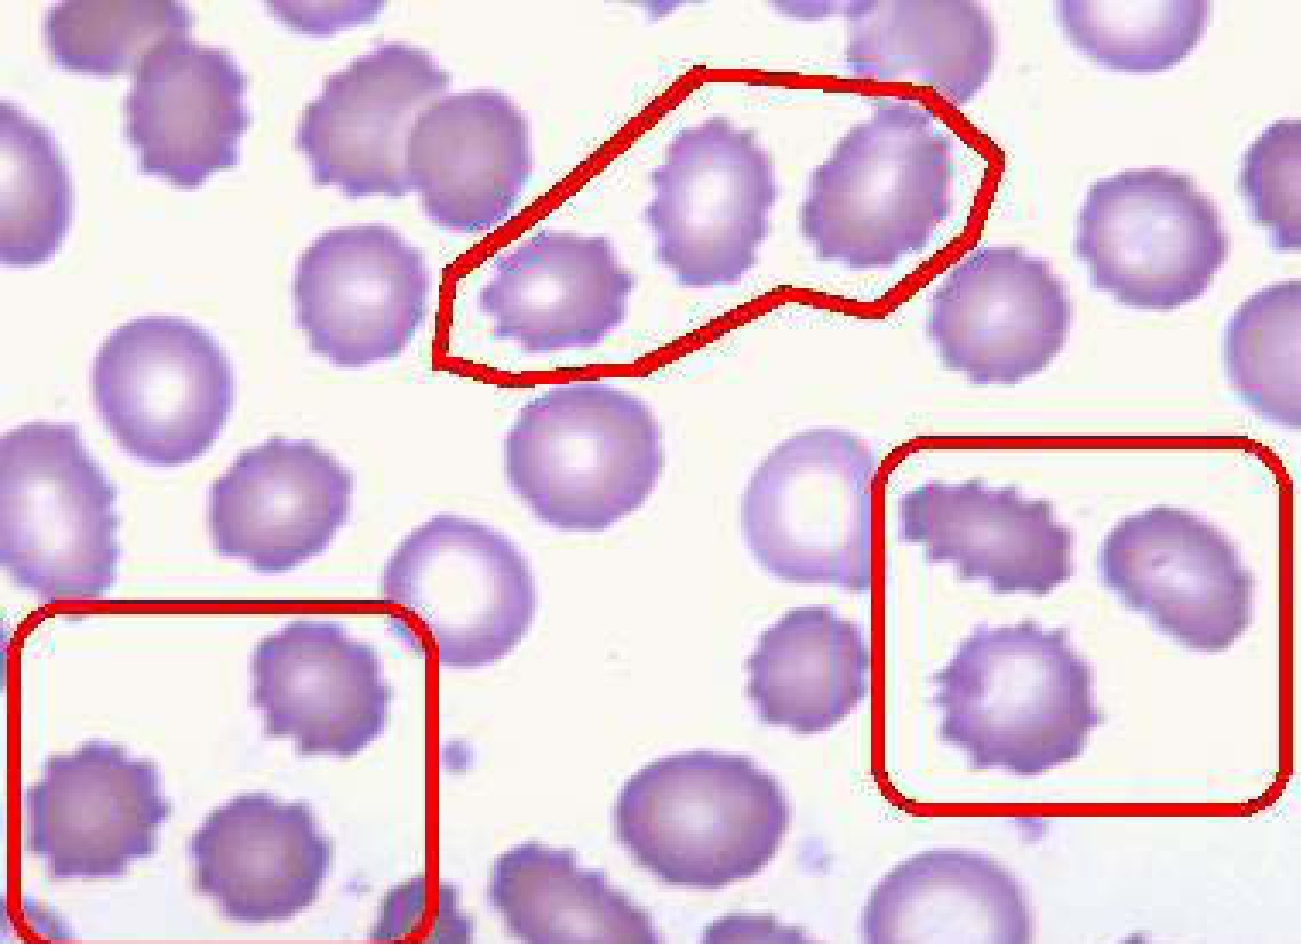
img83

4.常染色体隐性遗传的传递方式
既然常染色体隐性遗传容易导致一系列的遗传病,那么,由它引起的疾病都有哪几种呢?


苯丙酮尿症患者
(1)苯丙酮尿症:这种先天性代谢病是由于致病基因使人体肝脏内不能形成苯丙氨酸羟化酶,该酶能促使苯丙氨酸转化为酪氨酸,由于它的缺乏,导致苯丙氨酸的转化受阻,造成人体血液和其他组织中苯丙氨酸的积累。过量的苯丙氨酸和它的衍生物——苯丙酮酸就由尿中排出,所以称之为苯丙酮尿症。苯丙酮酸及其代谢产物如在脑中大量积累,会使脑组织的生化代谢紊乱,阻碍大脑的生长发育,造成智力低下,引起该症患者痴呆。另外,过量的苯丙氨酸及其代谢产物可能会抑制酪氨酸向黑色素的转化,故患者往往伴有肤色和发色较淡的性状表现。

黑尿症家族系谱图
(2)黑尿症:人体内酪氨酸的另一条重要代谢途径是转化成乙酰乙酸,后者再进一步分解成二氧化碳和水,使得尿液中无尿黑酸存在。但是,当由于基因缺陷造成尿黑酸氧化酶缺乏时,尿黑酸因不能被氧化分解而从尿中排出。尿黑酸本身并无颜色,但在空气中放置一段时间会变为黑色,于是尿液也随之变黑。碱性条件能促使尿黑酸更进一步变黑,这类患儿的尿布如果用肥皂来洗的话,就越洗越黑。不过,黑尿症是一种常染色体隐性遗传的良性病症,一般对患者危害不大,但有时也可使其软骨和关节等部位产生色素沉积,严重时会造成关节炎。

患高度白化病的女孩
(3)白化病:在正常人体内,酪氨酸还有一条重要的代谢途径,就是在酪氨酸酶的参与下,形成黑色素。黑色素使人的毛发呈现出黑色,长期从事野外劳动的人,其皮肤也会变得黝黑,这是因为阳光的照射加速了黑色素的形成,黑色素在皮肤细胞中沉着。黑色素可以吸收紫外线,减轻紫外线,减轻紫外线对人体的伤害。但是,如果控制酪氨酸合成酶的基因发生了隐性突变或从双亲那里得到的是两个隐性基因,这种人就不能合成酪氨酸酶,从而导致体内黑色素的形成受阻。缺乏黑色素,会使人体全身发白,就连头发、眉毛也是白的,这就是通常说的白化病,俗称“羊白头”。白化病患者的其他方面都正常,不像苯丙酮尿症那样会影响人的智力发育。这种人的唯一缺陷是怕日光的曝晒,尤其是眼睛特别畏光,平常见到的白化病人几乎都眯着眼睛,特别严重的还可因光线刺激过强而造成失明。

白化病患者
(4)先天性葡萄糖、半乳糖吸收不良症:患儿呈现腹泻、水样便,与尿很相似。腹泻的发生和程度与喂给糖的时间及量有关,给食后24小时出现腹泻,进食越多越严重,患儿通常进食量很大,所以体重下降很快。继而呈现脱水、失重、营养不良。患儿只要不以果糖作为主要糖类来源,就会出现腹泻,故要终身限制食用葡萄糖及半乳糖。但患儿随着年龄的增长对葡萄糖和半乳糖也会有所耐受。
(5)镰刀形红细胞贫血病:此病常被认为是常染色体隐性遗传,但更像不完全显性遗传。患者严重贫血,发育不良,关节、腹部和肌肉疼痛,多在幼年期死亡。但带有致病基因的杂合体大部分是无症状,或有的仅有轻度的贫血。但是,如果这种杂合体的人处于高原地区或长时间进行大强度运动训练而导致体内缺氧时,红细胞就会发生“镰变”,阻塞血管,引起全身发烧,肌肉酸痛,大量红细胞被脾脏吞噬,血红蛋白下降,机体运输O2和CO2的能力降低,造成机体红细胞被破坏和缺氧的恶性循环。据报道,这种杂合体的人在麻醉、输血、体力消耗等特殊情况下,会出现死亡。如:1970年,在美国的德克萨斯州有4个杂合体黑人新兵因应激反应而死亡。
(6)体位性(直)蛋白尿:此病患者肾脏无器质性病变,但如果长时间立性站立、行走、体力劳动,或进行大运动量训练时尿蛋白量增多,患者多系无力型体质。
(7)肝糖原贮积症:患儿于新生儿期即可出现进行性肝肿大,喂养困难,生长发育迟缓,2岁内易出现严重低血糖症,并伴有惊厥。患儿身矮、肌肉松弛且发育不良,颊和臀部脂肪组织增多,易患乳酸中毒、高脂血症,肝检查可见有大量糖原和脂质贮积。
(8)半乳糖血症:半乳糖血症是一种糖类代谢病。患儿出生后数日至数周即有呕吐、腹泻、黄疸症状,随之发生脱水、体重下降、肝损害,1~2个月后出现白内障。如不断奶,则会导致智力发育障碍,症状加剧。

半乳糖血症
正常婴儿体内的半乳糖经肠道吸收后,在肝内转变成1—磷酸葡萄糖而被利用。患儿因缺乏1—磷酸半乳糖尿苷转移酶,进含乳食物后,血中1—磷酸半乳糖及半乳糖浓度明显升高。1—磷酸半乳糖在肝脏积聚可引起肝肿大,肝功受损;在脑的积聚可引起运动及智力障碍。血中半乳糖升高可使葡萄糖释出减少,出现低血糖症;晶体内半乳糖增多,激活醛糖还原酶,产生半乳糖醇,引起白内障。
刺毛红细胞
(9)丙酮酸激酶缺乏症:婴儿型多在新生儿期即出现症状,黄疸与贫血都比较严重,黄疸可发生在出生后两天内,甚至需要换血。肝脾明显肿大,生长、发育受到障碍,重者常需多次输血才能维持生命。但随年龄增大,血红蛋白可以维持在低水平,不再需要输血。化验可见红细胞较大,非球型。红细胞丙酮酸激酶活性降低,常降至正常值的30%左右。此病纯合子发病,杂合子不显症状,故患者父母(携带者)的丙酮酸激酶活性也轻度降低。成人型症状很轻,常被忽视。多在合并感染时才出现贫血。
丙酮酸激酶是红细胞中的一种酶,其功能是在糖无氧酵解过程中起催化作用。如该酶缺乏可使红细胞内三磷酸腺苷的产生减少,从而影响红细胞的寿命,引起溶血性贫血。